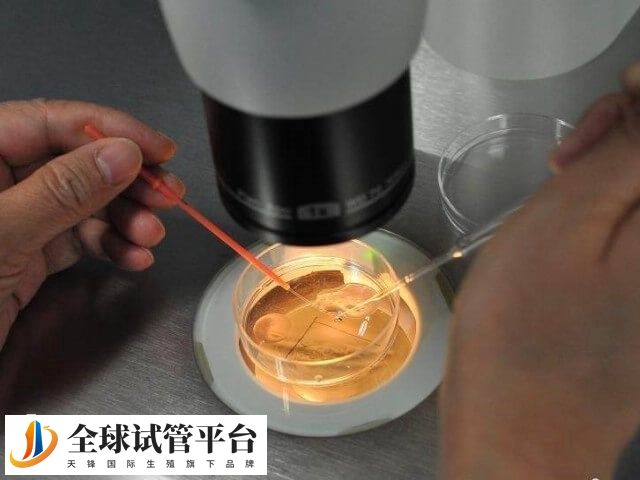
卵子质量差会影响胚胎的质量

对于高龄女性来说,由于年龄的增加,身体素质会出现下降,同时卵巢储备功能逐渐衰退,卵子的数量和质量都会显著下降,这时因精卵质量差,所以导致胚胎质量也比较差,从而也就容易使染色体异常的概率增加,如果移植这样的胚胎,那么可能会导致胚胎发育异常或流产,进而也就不容易成功怀孕。
高龄试管婴儿失败原因
试管婴儿技术确实是对不孕不育患者实现助孕的好方法,但是对于试管婴儿的成功率却一直都是大家所关心的,但是对于一些高龄患者来说,做试管婴儿却没有那么容易成功,反而总是出现失败,这具体的原因有以下几点。
1、卵子质量下降
随着年龄的增长,女性的卵巢储备功能逐渐衰退,卵子的数量和质量都会显著下降,这时配成的胚胎质量也会比较差,同时因高龄女性体内的雌激素水平较低,导致子宫内膜厚度不够,所以也会影响胚胎的着床率。
2、染色体异常
高龄女性随着年龄的增加,其卵子中染色体异常的概率增加,这时可能会导致配成的胚胎也存在染色体异常,而这些异常可能导致胚胎发育异常或流产。
3、心理压力大
高龄女性在尝试试管婴儿过程中可能面临更大的心理压力,长期的紧张和焦虑会影响身体的内分泌平衡,进一步影响试管婴儿的成功率。
4、身体机能下降
随着年龄的增长,身体的各项机能都会有所下降,所以这也就直接影响了受孕和胚胎着床的能力。






